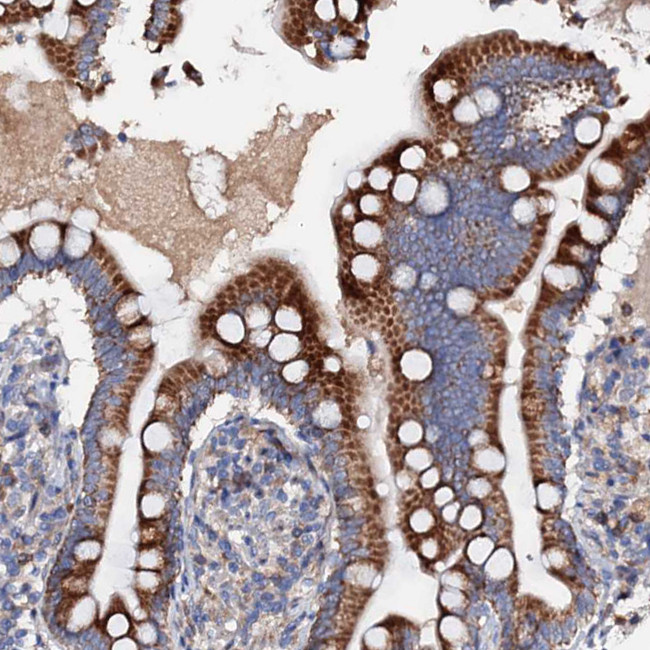
SLC10A7 Antibody in Immunohistochemistry (Paraffin) (IHC (P))
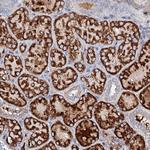
SLC10A7 Antibody in Immunohistochemistry (Paraffin) (IHC (P))

Search
Invitrogen
SLC10A7 Polyclonal Antibody
{{$productOrderCtrl.translations['antibody.pdp.commerceCard.promotion.promotions']}}
{{$productOrderCtrl.translations['antibody.pdp.commerceCard.promotion.viewpromo']}}
{{$productOrderCtrl.translations['antibody.pdp.commerceCard.promotion.promocode']}}: {{promo.promoCode}} {{promo.promoTitle}} {{promo.promoDescription}}. {{$productOrderCtrl.translations['antibody.pdp.commerceCard.promotion.learnmore']}}
产品信息
PA5-59022
种属反应
宿主/亚型
分类
类型
抗原
偶联物
形式
浓度
规格
纯化类型
保存液
内含物
保存条件
运输条件
RRID
产品详细信息
Immunogen sequence: LSITPINEWL LKGLQTVGCM PPPVSSAVIL TKAVGGNEAA AIFNSAFGSF LVSKHSLTCL LQL
Highest antigen sequence identity to the following orthologs: Mouse - 78%, Rat - 78%.
靶标信息
SLC10A7 (solute carrier family 10 (sodium/bile acid cotransporter family), member 7), also known as P7, is a 358 amino acid multi-pass membrane protein belonging to the sodium:bile acid symporter family. Existing as seven alternatively spliced isoforms, SLC10A7 is expressed at high levels in liver and lung, moderate levels in placenta, kidney, spleen, and thymus, and low levels in heart, prostate, and testis. A few members of the sodium:bile acid symporter family, such as NTCP (also known as SLC10A1) and Asbt (also known as SLC10A2), are involved in maintaining enterohepatic circulation of bile acids by mediating the first step of active bile transport through membrane barriers of liver and intestine. Other family members, including SLC10A6, play an important role in the cellular delivery of specific prohormones in testis, placenta, adrenal gland and other peripheral tissues. Orphan carriers such as SLC10A7 are uncharacterized and their functions unknown.
仅用于科研。不用于诊断过程。未经明确授权不得转售。
篇参考文献 (0)
生物信息学
蛋白别名: Na(+)/bile acid cotransporter 7; putative membrane transporter; SBF-domain containing protein; Sodium/bile acid cotransporter 7; solute carrier family 10 (sodium/bile acid cotransporter family), member 7; Solute carrier family 10 member 7; unnamed protein product
基因别名: C4orf13; P7; PSEC0051; SLC10A7; SSASKS
UniProt ID: (Human) Q0GE19
Entrez Gene ID: (Human) 84068